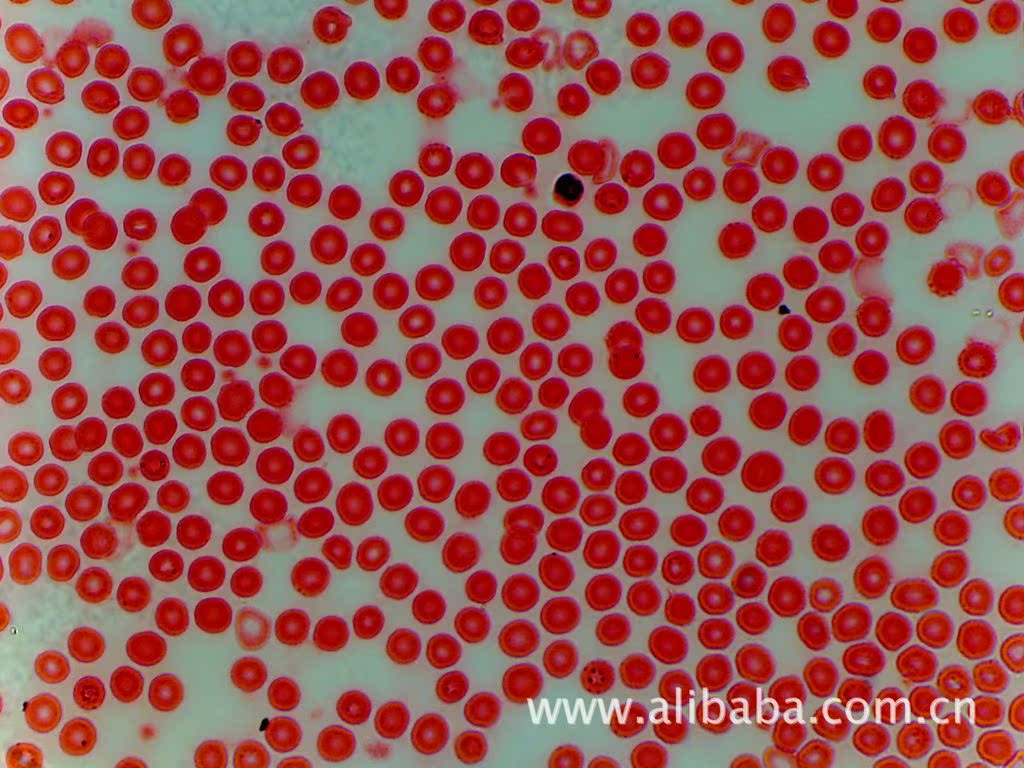

厂家直销500万像素USB显微镜数码摄像头CCD相机带测量支持win7
型号:KLN-CBY501


产品主要描述:
显微镜数码摄像头具有安装简便,通用性强,使用性价比高,功能齐全,简单易用等特点.使现有的普通光学显微镜立刻升级为数码显微镜.可通US线将显微镜下的图像传输至电脑进行实时显示,可满足大多数专业应用.
此摄像头为usb2.0接口500万像素摄像头,高帧率,高成像质量的专业级显微镜摄像头,支持低分辨率高速预览,全分辨率拍照.摄像头为C或者CS接口,能接各种显微镜以及各种工业检测镜头,并搭配我公司提供的动态测量软件,可满足医疗,教育,科研,工业生产,材料,化工,冶金矿产等行业对显微形态在PC上达到可视化操作的要求
产品主要特点:
1.产品小巧轻便,坚固耐用,性价比高
2.全系列产品使用统一软件平台,二次开发和安装非常方便
3.支持TWAIN和DirectShow接口
4.支持低分辨率高速预览,全分辨率拍照
5.独特的Rubber防尘结构
6.二次开发SDK包支持VC,VB,C#,Delphi,Labview,Halcon,OpenCV等
产品详细参数:
型号 | CBY501-H |
SENSOR型号 | MT9P006 |
SENSOR尺寸 | 1/2.5" CMOS彩色 |
有效像素 | 2592*1944(5M) |
分辨率和帧率 | 2592*1944:5.3FPS |
2048*1536(ROI):8FPS |
1920*1080(ROI):11.5 FPS |
1280*960(SUM):13 FPS |
1280*960(BIN):13FPS |
640*480(SUM):20 FPS |
640*480(BIN):20 FPS |
任意尺寸ROI |
像元尺寸 | 2.2um*2.2um |
扫描方式 | 逐行扫描 |
快门类型 | 电子滚动快门(ROLLING SHUTTER) |
曝光时间 | 0.120-3000ms |
图像数据格式 | Raw8/Raw10/Raw12可选 |
灵敏度 | 1.76V/Lux-sec(550nm) |
光谱响应 | 380nm-650nm(with IR-filter) |
信噪比 | 38.5dB |
动态范围 | 67.7dB |
清晰度 | 1100-1200线 |
曝光控制 | 自动/手动/区域曝光 |
产品固件更新 | 支持远程更新 |
拍照支持格式 | RAW,BMP,JPG,PNG |
可编程控制 | 相机工作速度,图像尺寸,拍照模式,图像亮度,曝光时间,增益,消频闪,GAMMA,对比度,黑平衡,锐度 |
支持系统 | Windows XP(32位); Win7(32/64位) ; Win8(32/64位) |
支持软件接口 | TWAIN,DirectShow |
数据接口 | USB2.0 480Mb/s |
产品指示 | LED上电和待机常亮,工作闪烁 |
功耗 | 工作小于0.8W,待机约0.3W |
产品供电 | USB5V供电(无外部供电电路) |
工作温度 | 0-50C |
存储温度 | -20C-60C |
工作湿度 | 10%-90%RH(无凝结) |
存储湿度 | 10%-60%RH |
镜头接口 | C/CS接口 |
外观尺寸 | 45*48*36.4mm(不包括延长环和外部固定块) |
产品重量 | 约100g |
安装方法
1.C接口显微镜安装如图,直接把摄像头的接口拧到显微镜的螺纹上。

2.光滑无螺纹镜筒双目显微镜和三目显微镜安装软如图。装配好适配镜,可以安装到三目上或者双目上

软件描述:(通用测量软件,可调节图像,帧率,ROI窗口,实现预览分辨率和拍照分辨率分开设置)

SDK的应用:

Labview和其他软件的兼容:


公司质量证书:
符合欧盟出口标注你的CE和ROHS证书:


仓库一角:

包装清单:
数码摄像头 一个
USB线 一根
驱动软件光盘 一张
运送方式:
由于显微镜摄像头和相关镜头都是高精度易碎产品,所以一般我们选择顺丰快递,但也不排除其他快递。
售后服务:
本公司产品自销售之日起,质保 一年。终身提供软件的更新和维护,请广大消费者放心购买。
拍摄图片预览![]()

其他显微镜相关产品
200万像素VGA接口显微镜CCD


1080P 高清 HDMI接口显微镜数码摄像头CCD


其他显微镜相关产品










本店销售量虽然不大,因为我公司以外贸为主,很少在网上直接
销售,但是服务态度和专业水平一流,收到广大买家的好评:


更多信息请访问我司网站:/
淘宝用户请到我司淘宝店铺购买:
在线沟通:QQ,642488868